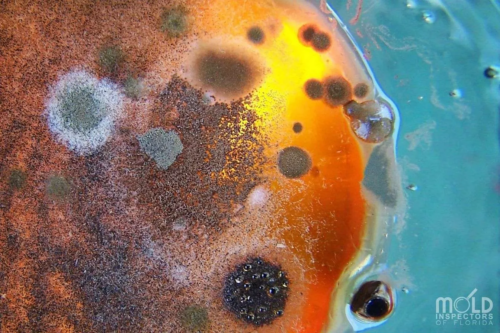
toxic mold

Your home is meant to be a safe haven, a place where you can unwind and relax without worries. However, lurking within the walls and corners of your living space, there could be a silent and dangerous intruder: toxic mold.
Mold is not just an unsightly nuisance; it can pose serious health risks to you and your family. What’s even more unsettling is that mold can grow in unexpected and often hidden places, making it challenging to detect and eliminate.
In this article, we delve into the unsettling reality of toxic mold and reveal the top 10 alarming places it might be hiding in your home right now. From the damp corners of your bathroom to the inconspicuous recesses of your kitchen, mold might be silently proliferating.
But fret not; armed with the right knowledge and action plan, you can take control of this potentially hazardous situation. Join us as we uncover these covert mold hotspots and provide you with essential insights on how to promptly and effectively rid your home of this hidden menace.
Your family’s well-being and the health of your living environment are at stake – it’s time to unveil the truth about where toxic mold is lurking and how to banish it from your home for good.
What Is Toxic Mold?
Toxic mold, scientifically known as Stachybotrys chartarum, is a type of mold that produces mycotoxins, which are toxic substances that can have harmful effects on human health. These molds thrive in environments with excess moisture, such as damp and humid conditions, and they typically grow on materials rich in cellulose, like wood, paper, and drywall.
Toxic mold is known for its dark greenish-black color, although it can sometimes appear in other colors as well.
Symptoms Of Toxic Mold Exposure
Exposure to toxic mold and its mycotoxins can lead to a range of health issues, especially in individuals with weakened immune systems, allergies, or respiratory conditions. Common symptoms of exposure to toxic mold include respiratory problems like coughing, wheezing, and sinus congestion, as well as skin irritation, headaches, and allergic reactions. In severe cases, toxic mold exposure can lead to more serious health problems, such as chronic fatigue, neurological issues, and even organ damage.
It’s important to note that not all molds are toxic, and the presence of mold in your home doesn’t necessarily mean it’s toxic mold. However, any type of mold growth should be taken seriously, as mold can worsen indoor air quality and potentially cause health problems, especially if left untreated.
Preventing and addressing mold growth involves controlling moisture levels within your home, promptly addressing water leaks or flooding, improving ventilation, and keeping indoor spaces clean and dry. If you suspect toxic mold is present in your home, it’s advisable to seek professional help for proper identification and safe removal, as handling mold improperly can lead to further spread and exposure to harmful mycotoxins.
Where Does Toxic Mold Grow?
Toxic mold can grow in various areas within your home where moisture and favorable conditions are present. Here are 10 places where toxic mold might hide:
- Basements and Cellars: These areas often have higher humidity levels and can be prone to water leaks or flooding, providing an ideal environment for mold growth.
- Bathrooms: Mold can thrive in bathrooms due to the combination of high humidity, moisture from showers and baths, and poor ventilation.
- Kitchens: Areas around sinks, dishwashers, and refrigerators can become breeding grounds for mold due to water leaks and spills.
- Attics: Poor insulation and ventilation in attics can lead to trapped moisture, which encourages mold growth on wooden structures and insulation.
- Crawlspaces: Like basements, crawlspaces can experience high humidity and moisture levels, promoting mold growth on building materials and insulation.
- Under Sink Cabinets: Leaky pipes or plumbing fixtures under sinks can create a moist environment that fosters mold growth.
- Window Sills and Frames: Condensation can accumulate on windows, providing moisture for mold to grow on wooden frames and sills.
- Around Pipes: Pipes that have condensation or leaks can create damp areas, making them susceptible to mold growth.
- Laundry Rooms: Clothes dryers that are not properly vented can lead to humid conditions, potentially promoting mold growth in laundry areas. Washing machines can also be a breeding ground for toxic mold.
- Closets: Poor ventilation and lack of sunlight in closets can create a conducive environment for mold to develop on clothing, shoes, and stored items.
Remember, the key to preventing toxic mold growth is to control moisture and maintain proper ventilation throughout your home. Regular inspections, prompt repairs of leaks, and maintaining optimal humidity levels can help deter mold growth in these and other vulnerable areas. If you suspect mold growth, especially toxic mold, it’s advisable to consult with professionals for proper assessment and safe removal.
Natural Ways To Kill Toxic Mold & Prevent It From Coming Back
Dealing with toxic mold requires careful attention and appropriate measures to ensure effective removal and prevention. While natural methods can be helpful for minor cases of mold growth, it’s important to note that for serious mold infestations, consulting with professionals is recommended. Here are some natural ways to address toxic mold and prevent its recurrence:
1. White Vinegar: Vinegar is known for its mild antifungal properties. Mix equal parts of white vinegar and water in a spray bottle and apply it to moldy areas. Let it sit for an hour, then scrub the area with a brush before wiping it clean. The acetic acid in vinegar helps kill mold and prevent its growth. Doing this regularly in constantly moist areas can prevent mold from growing.
2. Tea Tree Oil: Tea tree oil has natural antifungal and antibacterial properties. Add a few drops of tea tree oil to a spray bottle filled with water. Shake well and spray it on mold-infested areas. Allow it to sit for a while before wiping clean. Tea Tree Oil has a pleasant smell and can be used in many other treatments. Click Here To Check Out Starwest Botanicals Organic Tea Tree Oil.
3. Baking Soda: Baking soda is effective for removing mold and deodorizing the area. Mix 1 teaspoon of baking soda with water to create a paste. Apply the paste to the moldy surface, scrub gently, and then rinse with water. This Baking Soda By Starwest Botanicals Is The Highest Quality You’ll Find.
4. Hydrogen Peroxide: Hydrogen peroxide is a mild antifungal and can be used to kill mold on hard surfaces. Use a 3% hydrogen peroxide solution and spray it on the moldy area. Let it sit for 10 minutes before scrubbing and wiping clean.
5. Lemon Juice: Lemon juice’s natural acidity can help break down mold. Apply freshly squeezed lemon juice to the moldy surface and let it sit for a while. Scrub the area and rinse with water.
6. Borax: Borax is a natural mineral with fungicidal properties. Mix 1 cup of borax with 1 gallon of water and use it to scrub moldy surfaces. Rinse thoroughly after cleaning.
Preventive Measures:
1. Reduce Moisture: Mold thrives in damp environments, so the best prevention is to keep your home dry. Fix leaks promptly, use exhaust fans in bathrooms and kitchens, and ensure proper ventilation in areas prone to moisture buildup.
2. Control Humidity: Use dehumidifiers to maintain indoor humidity levels between 30% and 50%. This prevents excessive moisture that encourages mold growth.
3. Proper Ventilation: Ensure good air circulation throughout your home. Open windows and use fans to allow air to flow and prevent stagnant, humid conditions.
4. Regular Cleaning: Regularly clean and dust your home to prevent the buildup of organic materials that mold feeds on.
5. Use Mold-Resistant Materials: When renovating or building, consider using mold-resistant materials in areas prone to moisture, such as bathrooms and basements.
6. Monitor Indoor Plants: Keep an eye on indoor plants, as mold can grow in their soil and on their surfaces. Make sure plant pots have proper drainage and avoid overwatering.
Remember that while natural methods can help with small-scale mold issues, larger infestations or toxic mold cases require professional assessment and remediation to ensure the safety of your home and health.
In Conclusion:
As we’ve explored the alarming places where mold can thrive, it’s clear that this issue goes beyond mere aesthetics. The health risks posed by toxic mold growth are significant, making it crucial to understand its hiding spots and effective eradication methods.
By embracing natural remedies such as vinegar, tea tree oil, baking soda, and more, we can address smaller mold issues while minimizing our impact on the environment. However, for serious cases, it’s essential to seek professional assistance to ensure comprehensive removal and remediation.
Prevention, however, proves to be the true key to dealing with toxic mold. Through vigilant maintenance, moisture control, proper ventilation, and the use of mold-resistant materials, we can create an environment that is inhospitable to mold growth.
By implementing these preventive measures, we’re not just ridding our homes of mold – we’re creating healthier living spaces for ourselves and our loved ones.
Ultimately, the battle against toxic mold is one we cannot afford to overlook. Armed with the knowledge of its hiding places and armed with the tools for both remediation and prevention, we can reclaim our homes from this hidden menace and ensure a safer, healthier living environment for years to come.
